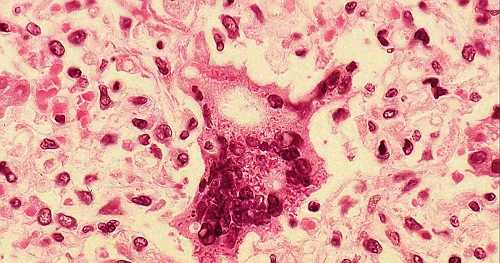
Measles outbreak at Florida university climbs to nearly 60 cases

Measles Outbreak at Florida University Reaches Alarming Numbers
A measles outbreak at a university in Florida has reached alarming numbers, with nearly 60 cases reported this week. The outbreak has left health officials scrambling to contain the spread of the highly contagious disease.
A measles outbreak at a university in Florida has reached alarming numbers, with nearly 60 cases reported this week. The outbreak has left health officials scrambling to contain the spread of the highly contagious disease.Measles Outbreak Hits Ave Maria University
The measles outbreak is centered at Ave Maria University near Naples, Florida. According to reports, the university has seen a significant increase in cases over the past week, with nearly 60 students and staff members affected. The outbreak has raised concerns about the spread of the disease on campus.
Health Officials Scramble to Contain Spread
Health officials are working closely with university administrators to contain the spread of the measles virus. They are urging anyone who may have been exposed to the disease to seek medical attention immediately. The outbreak has also raised concerns about the effectiveness of vaccination efforts on campus.
Measles Cases Continue to Soar
The number of measles cases at Ave Maria University continues to rise, with nearly 60 cases reported this week. This is a stark reminder of the importance of vaccination and the need for continued public health efforts to prevent the spread of infectious diseases.
The measles outbreak at Ave Maria University serves as a stark reminder of the ongoing threat posed by infectious diseases. As we continue to navigate the challenges of public health, it is essential that we prioritize vaccination efforts and take proactive steps to prevent the spread of disease.
Topic Live















